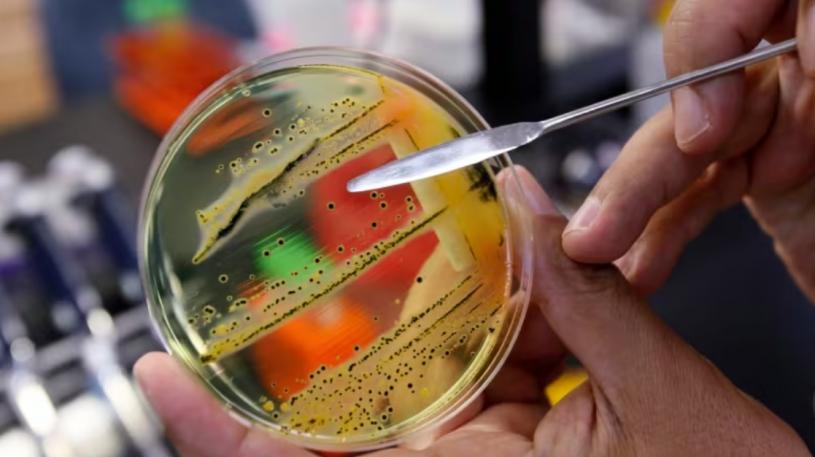

沙门氏菌感染8省已70例一死 去过有蛇或囓齿宠物空间也中招
【星岛综合报道】加拿大公共卫生当局表示,正在调查至少两年前开始爆发的沙门氏菌感染致死病例,结果发现个案接触作为宠物的蛇和囓齿动物之间有明显相关。
据CTV报道,加拿大公共卫生署(Public Health Agency of Canada,简称PHAC)表示,截至3月19日,已有70例沙门氏菌确诊病例与单次爆发感染有关。PHAC在新闻稿中写道:“已有10人入院治疗,一人死亡,省级公共卫生局已确认沙门氏菌是死因。”
全国已有8个省发现了有关病例,包括卑诗、亚省、沙省、缅省、安省、魁省、纽奔驰域省、纽芬兰和拉布拉多省。患者在 2022年2月至2024年2月期间遭到感染。
卫生官员称,许多病患事前曾与宠物蛇或囓齿动物有直接或间接接触。有些人虽然没有直接接触这些动物,但是住在饲养蛇或囓齿动物的同一间房屋内。新闻稿说:“尚未确定这些饲养的蛇或囓齿动物是否出自单一供应商。”
由于全国沙门氏菌病例增加,这项调查于去年春天首次启动。
基因组定序发现,追溯至2022年的病例是由2023年和2024年报告的疾病中发现的同一菌株所引起。该机构表示,有些人可能在实际患病一段时间后,才就医发现自己遭到感染。
卫生署表示,其数据是基于人们报告病情的时间,而不一定是他们生病的时间。
感染沙门氏菌患者通常在接触后6至72小时内出现症状,可能包括发烧、呕吐、头痛和腹部绞痛。
新闻稿中写道:“如果接触爬行动物和囓齿动物、牠们的食物和环境,然后在不洗手的情况下触摸你的脸、眼睛或嘴巴,你可能就会感染沙门氏菌。”
当局说明:“你也可能透过接触饲养蛇和囓齿动物的家庭,或展览中受污染的表面或物体而生病。这种情况可能发生在生日派对、学校或日托、博物馆、科学中心、动物园或巡回爬行动物表演中。”
图:美联社/加通社资料图片
V02
---------------------------------------------
>>>星岛网WhatsApp爆料热线(416)6775679,爆料一经录用,薄酬致意。
>>>立即浏览【移民百答】栏目:新移民抵埗攻略,老华侨也未必知道的事,移民、工作、居住、食玩买、交通、报税、银行、福利、生育、教育。
>>>星岛网WhatsApp爆料热线(416)6775679,爆料一经录用,薄酬致意。
>>>立即浏览【移民百答】栏目:新移民抵埗攻略,老华侨也未必知道的事,移民、工作、居住、食玩买、交通、报税、银行、福利、生育、教育。
×